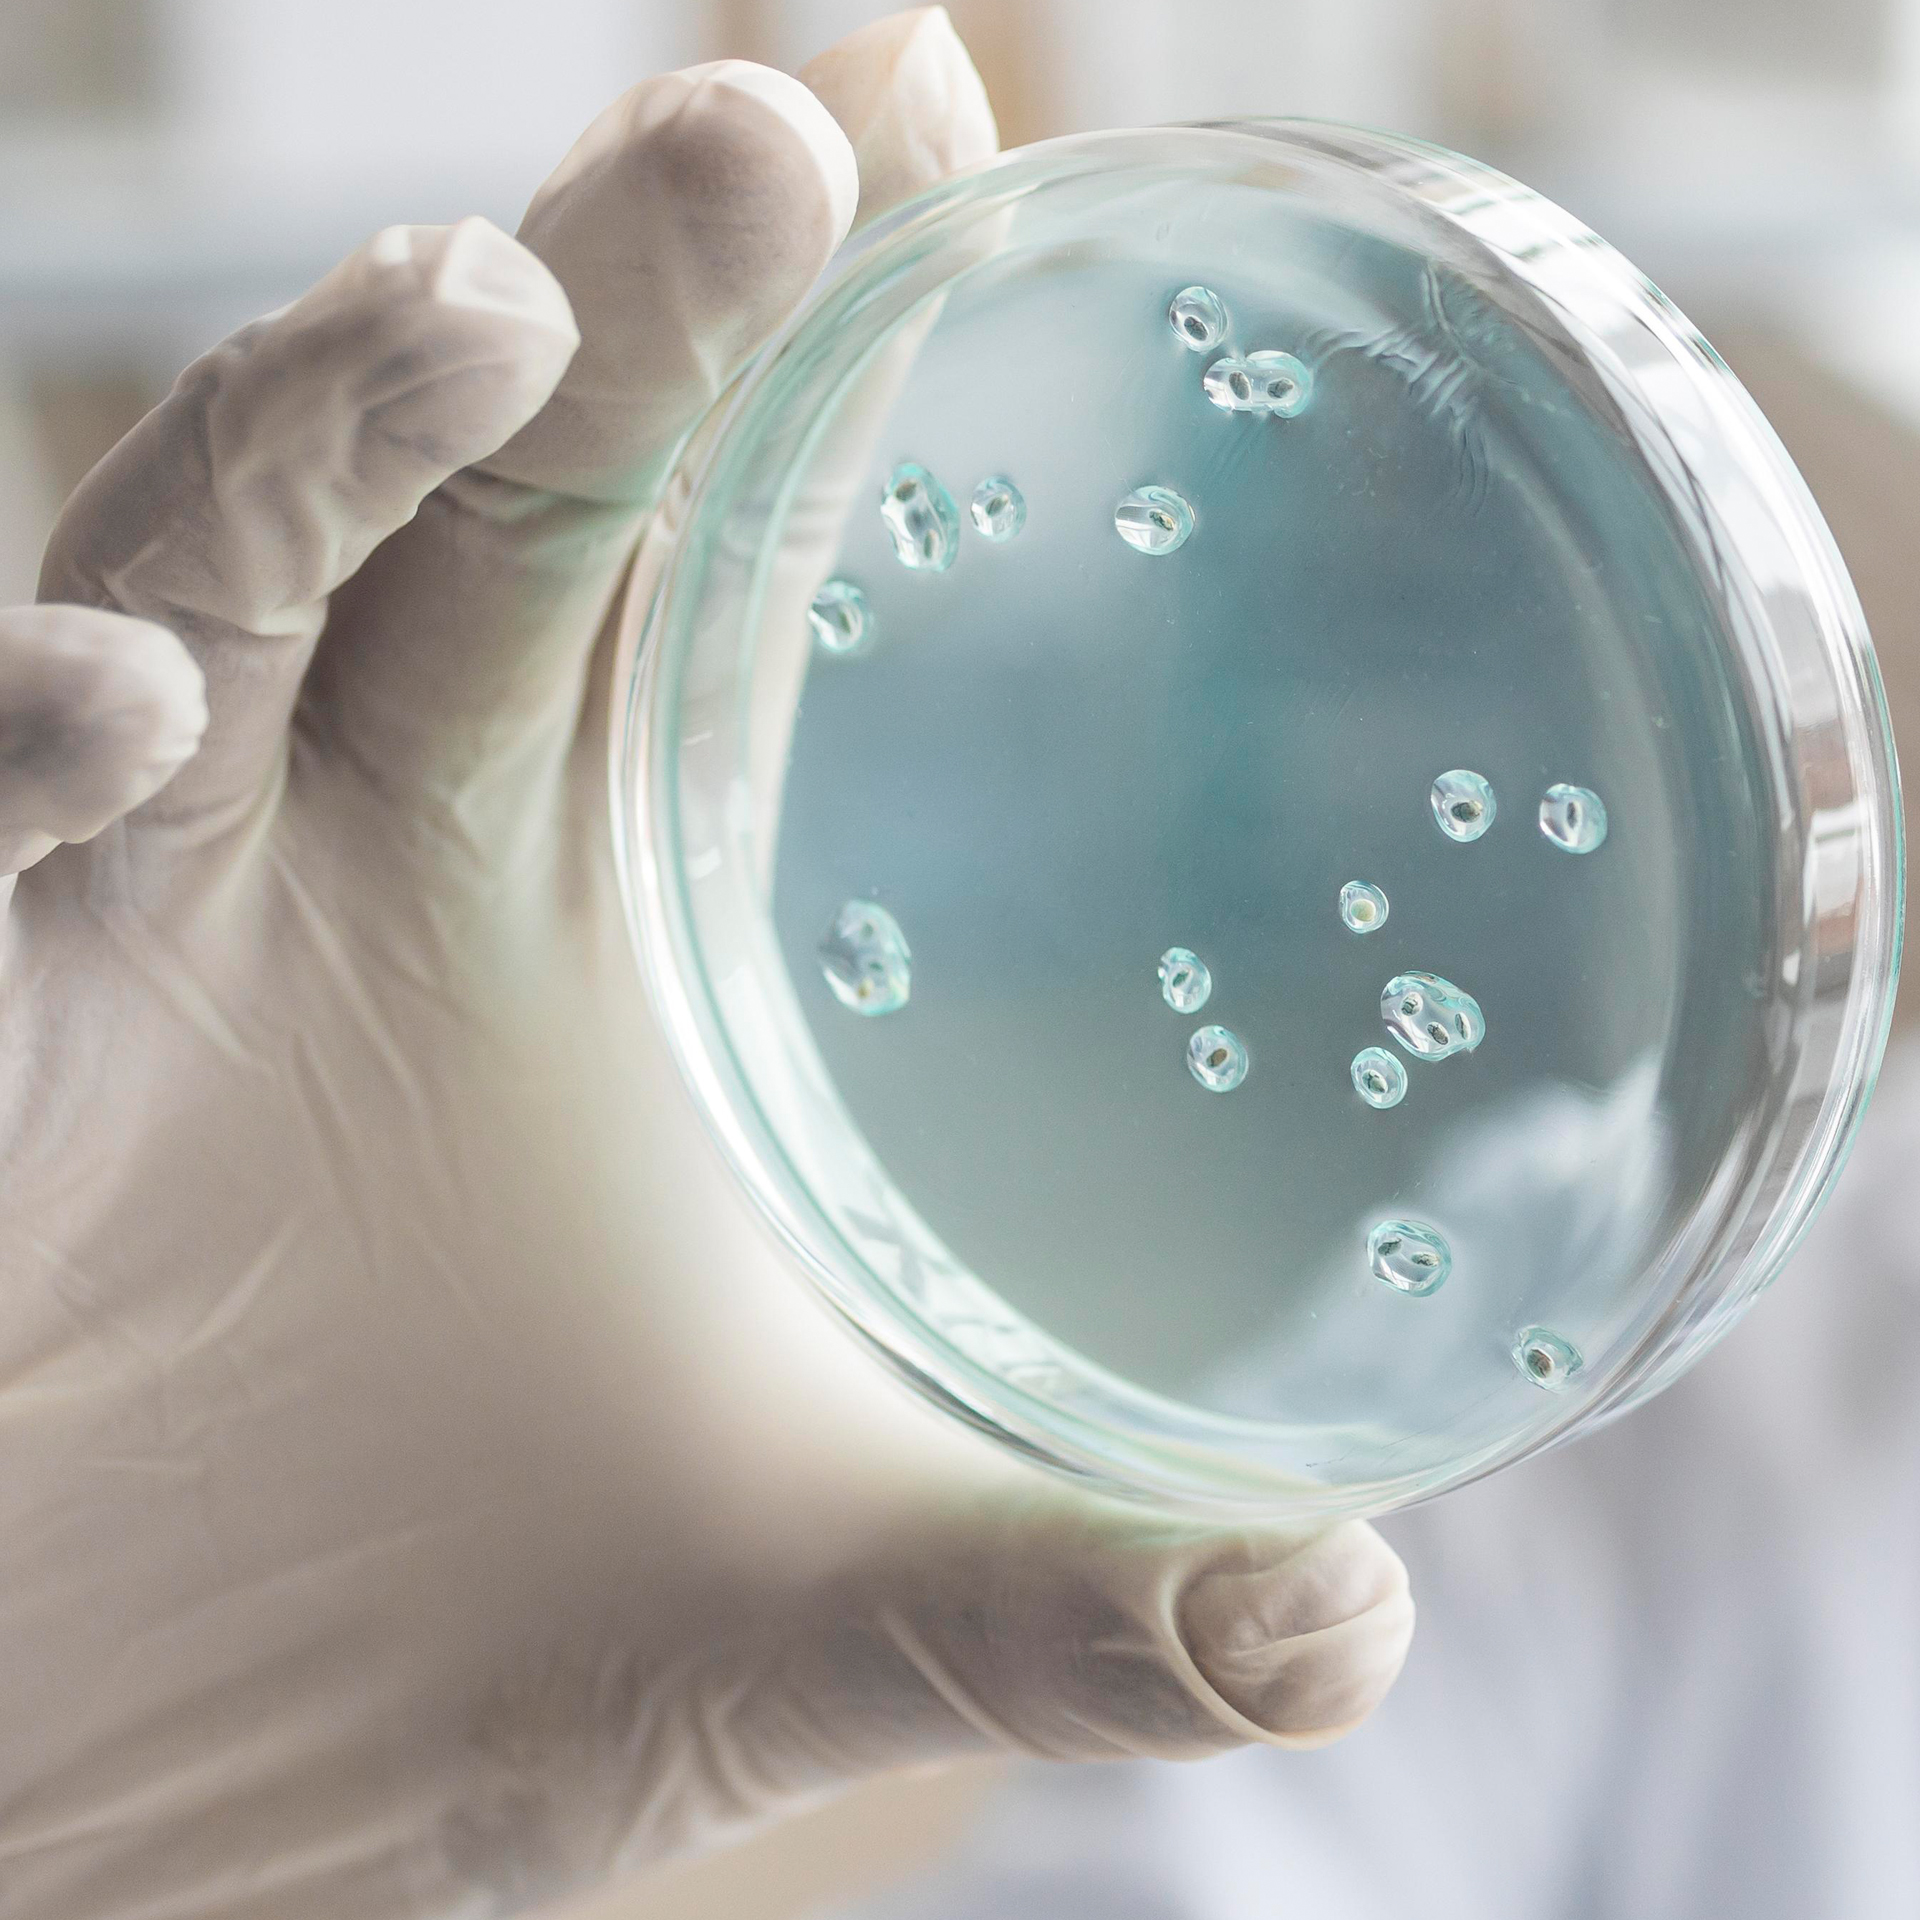

La misión principal del Instituto de Ciencias de la Salud de la Universidad de O’Higgins es realizar investigación que busque dar respuestas a las necesidades de salud de la Región y del país, que se caracterice por ser pertinente y útil, de tipo multidisciplinario y vinculado a redes de colaboración internacional. Este conocimiento pondrá la creación e innovación al servicio de las personas y del desarrollo regional, con proyección nacional e internacional.
El Instituto de Ciencias de la Salud también contribuirá a la formación de profesionales de la salud con gran compromiso social, con sólidas bases científicas y un fuerte sentido público.